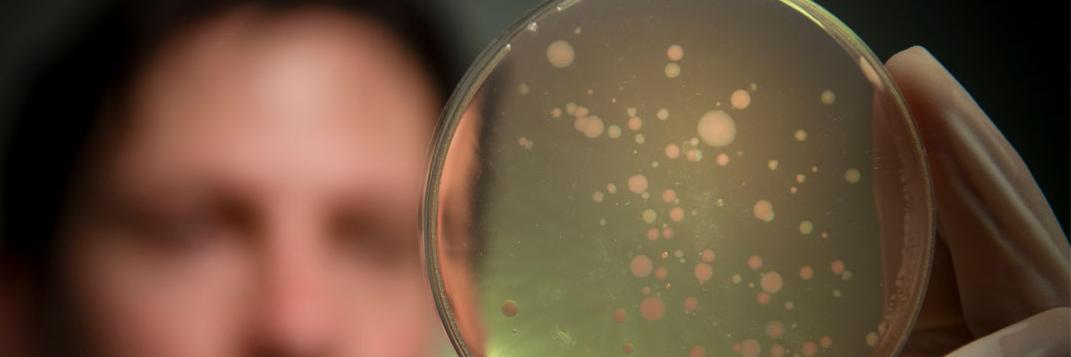
Forster Lab banner

Forster Lab
52 posts

@Forster_Lab
The Microbiota and Systems Biology Laboratory at @Hudson_Research & @Monash_FMNHS Our research focuses on the human #microbiota and #microbiome based medicines


















Meet the 2022 #Microbiome interaction in health and disease poster conference prize winner! 📜🏅#MIHD22 👏Congratulations to Remy Young, from @Hudson_Research, for her winning contribution on "Dietary compounds as drivers of gastrointestinal microbiome dynamics" [P37]💭🙌








New #PhD opportunity @monashnutrition! Understand the association between food-based micro-organisms and gastrointestinal bacteria, and how we can apply this knowledge to develop microbiome-based therapies. ow.ly/FzGv50Gl5Z4







#BigData & “Omics” technologies are all the rage in medical research. While they provide potential for precision/personalized medicine, this all in fact remains largely aspirational. D'Adamo et al @Hudson_Research @CiiiD_Hudson review the future of "Omics" onlinelibrary.wiley.com/doi/10.1111/im…



If you enjoyed last week's #viinyis, please consider joining us at #lorneiandi, which is moving online for 2021. We still have amazing speakers, subsidised registrations for students & Career Development Awards for #ecrs. To submit your abstract: lorneinfectionimmunity.org #science





